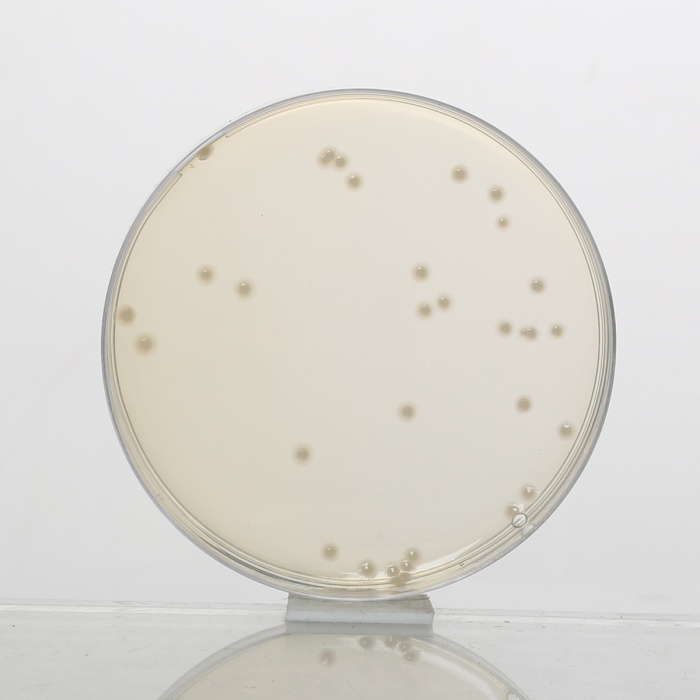

Your enquiry has been submitted
Mueller Hinton Agar
Intended Use
Recommended for determination of susceptibility of microorganisms to antimicrobial agents isolated from clinical samples.
Composition**
| Ingredients | g / L |
|---|---|
| HM infusion solids B # (from 300g) | 2.000 |
| Acicase ## | 17.500 |
| Starch | 1.500 |
| Agar | 17.000 |
Final pH (at 25°C): 7.3±0.1
**Formula adjusted, standardized to suit performance parameters
# - Equivalent to Beef heart infusion
## - Equivalent to Casein acid hydrolysate
Directions
Suspend 38.0 grams in 1000 ml purified/ distilled water. Heat to boiling to dissolve the medium completely. Sterilize by autoclaving at 15 lbs pressure (121°C) for 15 minutes. Cool to 45-50°C. Mix well and pour into sterile Petri plates.
Note: The performance of this batch has been tested and standardised as per the current CLSI (formerly, NCCLS) document M6-protocols for Evaluating Dehydrated Mueller Hinton Agar.
Principle And Interpretation
The Mueller Hinton formulation was originally developed as a simple, transparent agar medium for the cultivation of pathogenic Neisseria species (1). Other media were subsequently developed that replaced the use of Mueller Hinton Agar for the cultivation of pathogenic Neisseria species, but it became widely used in the determination of sulfonamide resistance of gonococci and other organisms. Mueller Hinton Agar is now used as a test medium for antimicrobial susceptibility testing (2). Mueller Hinton Agar is recommended for the diffusion of antimicrobial agents impregnated on paper disc through an agar gel as described in CLSI Approved Standard (3). Mueller Hinton Agar has been selected by the CLSI for several reasons:
- It demonstrates good batch-to-batch reproducibility for susceptible testing.
- It is low in sulfonamide, trimethoprim and tetracycline inhibitors.
- It supports the growth of most non-fastidious bacterial pathogens and
- Many data and much experience regarding its performance have been recorded (4).
Kirby-Bauer et al recommended this medium for performing antibiotic susceptibility tests using a single disc of high concentration (5). WHO Committee on Standardization of Susceptibility Testing has accepted Mueller Hinton Agar for determining the susceptibility of microorganisms because of its reproducibility (6). Mueller Hinton Agar with 5% sheep blood and Mueller Hinton Agar with Hemoglobin have been recommended for antimicrobial susceptibility testing of Streptococcus pneumoniae and Haemophilus influenzae.
HM infusion B from and acicase provide nitrogenous compounds, carbon, sulphur and other essential nutrients. Starch acts as a protective colloid against toxic substances present in the medium. Starch hydrolysis yields dextrose, which serves as a source of energy. These ingredients are selected for low thymine and thymidine content as determined by MIC values for Enterococcus faecalis with sulfamethoxazole trimethoprim (SXT).
The Kirby-Bauer procedure is based on agar diffusion of antimicrobial substances impregnated on paper discs. This method employs disc with a single concentration of antimicrobial agent and the zone diameters observed are correlated with minimum inhibitory concentration (MIC) values (7,1,2). A standardized suspension of the organism is swabbed over the entire surface of the medium.
Paper discs impregnated with specific amounts of antimicrobial agents are then placed on the surface of the medium, incubated and zones of inhibition around each disc are measured. The susceptibility is determined by comparing with CLSI standards (4). The various factors, which influence disc diffusion susceptibility tests, are agar depth, disc potency, inoculum concentration, pH of the medium and beta-lactamase production by test organisms (4,8).
Mueller Hinton Agar is not appropriate for assay by disc diffusion method with slow growing organisms, anaerobes and capnophiles. With slow growing organisms, increased incubation may cause deterioration of diffusing antibiotic and produce unprecise readings (9). Mueller Hinton Agar is recommended for the diffusion of antimicrobial agents impregnated on paper disc through an agar gel as described in NCCLS (National Committee for Clinical Laboratory Standards), now CLSI (Clinical and Laboratory Standards Institute) Approved Standard (10).
Type of specimen
Clinical samples: Pure cultures isolated from urine, stool, blood etc.
Specimen Collection and Handling
For clinical samples follow appropriate techniques for handling specimens as per established guidelines (2,10-13). After use, contaminated materials must be sterilized by autoclaving before discarding.
Warning and Precautions
In Vitro diagnostic use only. For professional use only. Read the label before opening the container. Wear protective gloves/protective clothing/eye protection/face protection. Follow good microbiological lab practices while handling specimens and culture. Standard precautions as per established guidelines should be followed while handling clinical specimens. Safety guidelines may be referred in individual safety data sheets.
Limitations
- This medium is recommended for susceptibility testing of pure cultures only.
- Inoculum density may affect the zone size. Heavy inoculum may result in smaller zones or too less inoculum may result in bigger zones.
- Fastidious organisms may not grow on this medium and may require supplementation of blood.
- Fastidious anaerobes may not grow on this medium.
- As antimicrobial susceptibility is carried with antibiotic disc, proper storage of the disc is desired which may affect the potency of the disc.
- Under certain circumstances, the in vitro results of antibiotic susceptibility may not show the same in vivo.
Performance and Evaluation
Performance of the medium is expected when used as per the direction on the label within the expiry period when stored at recommended temperature.
Quality Control
Appearance: Cream to yellow homogeneous free flowing powder
Gelling: Firm, comparable with 1.7% agar gel.
Colour and Clarity of prepared medium: Light amber coloured clear to slightly opalescent gel forms in Petri plates
Reaction: Reaction of 3.8% w/v aqueous solution at 25°C. pH : 7.3±0.1
pH: 7.20-7.40
Cultural Response
Antibiotic susceptibility tests are performed in accordance with, and meet the acceptance limits of the current ISO/TS 16782 (15). Performance of the medium is checked in accordance with the CLSI/ EUCAST guidelines.
For testing S. pneumoniae : The medium was supplemented with 5% Horse blood and 20 mg/l NAD, incubated at 34-36°C for 18-20 hours in 5% CO2.
For testing H. influenzae : The medium was supplemented with 5% Horse blood and 20 mg/l NAD, incubated at 34-36°C for 18-20 hours in 5% CO2.
Antibiotic Sensitivity test
Various discs were tested for standard ATCC strains and zone of inhibition were measured after an incubation 30-35°C for 18 hours. (As per the latest CLSI Protocol M6 & Standards as per the current CLSI M100).
Thymine/Thymidine Content
# The zones for these discs are indicative of the Thymine/Thymidine content of the medium.
Divalent Cation Content
$ The zones for these discs are indicative of the Divalent Cation content of the medium
| Organism | Growth | Antimicrobial Agent / Disc Content | Zone Diameter | Incubation |
|---|---|---|---|---|
| Escherichia coli ATCC 25922 (00013*) | luxuriant | Cephalothin CEP 30mcg | 15-21 mm | 34-36°C 16-20 hours |
| Ampicillin AMP 10mcg | 15-22 mm | |||
| Chloramphenicol C 30 mcg | 21-27 mm | |||
| Gentamicin GEN 10mcg | 19-26 mm | |||
| Co-Trimoxazole (COT) 25 mcg | 23-29 mm | |||
| Sulphafurazole SF 300 mcg | 15-23 mm | |||
| Cefotaxime CTX 5 mcg | 25-31 mm | |||
| Tigecycline TGC 15mcg | 20-27 mm | |||
| Tetracycline TE 30 mcg | 18-25 mm | |||
| Amoxicillin-clavulanate AMC 30 mcg | 18-24 mm | |||
| Ciprofloxacin CIP 5mcg | 29-38 mm | |||
| Escherichia coli ATCC 35218 | luxuriant | Amoxicillin-clavulanate AMC 30 mcg | 17-22 mm | 34-36°C 16-20 hours |
| Piperacillin/Tazobactam PIT 100/10 mcg | 24-30 mm | |||
| Ticarcillin TI 75 mcg | 6 mm | |||
| Ticarcillin/Clavulanic acid TCC 75/10mcg | 21-25 mm | |||
| Ampicillin AMP 10 mcg | 6 mm | |||
| Ampicillin/Sulbactam A/S 10/10 mcg | 13-19 mm | |||
| Staphylococcus aureus subsp. aureus ATCC 25923 (00034*) | luxuriant | Erythromycin E 15 mcg | 22-30 mm | 34-36°C 16-20 hours |
| Linezolid LZ 30 mcg | 24-30 mm | |||
| Tetracycline TE 30 mcg | 24-30 mm | |||
| Ciprofloxacin CIP 5mcg | 22-30 mm | |||
| Amoxyclav (AMC) 30 mcg | 28-36 mm | |||
| Co-Trimoxazole COT 25 mcg | 24-32 mm | |||
| Cefoxitin CX 30 mcg | 23-29 mm | |||
| Oxacillin OX 1mcg | 18-24 mm | |||
| Pristinomycin RP 15 mcg | 21-28 mm | |||
| Gentamicin GEN 10 mcg | 19-27 mm | |||
| Penicillin-G 10 units | 26-37 mm | |||
| Ampicillin/Sulbactam A/S 10/10 mcg | 29-37 mm | |||
| Staphylococcus aureus subsp. aureus ATCC 29213 (00131*) | luxuriant | Penicillin-G P 1 unit | 12-18 mm | 34-36°C 16-20 hours |
| Cefoxitin CX 30 mcg | 24-30 mm | |||
| Erythromycin E 15 mcg | 23-29 mm | |||
| Linezolid LZ 10 mcg | 21-27 mm | |||
| Gentamicin GEN 10 mcg | 19-25 mm | |||
| Tetracycline TE 30 mcg $ | 23-31 mm | |||
| Ciprofloxacin CIP 5mcg | 21-27 mm | |||
| Staphylococcus aureus subsp. aureus ATCC 43300 (MRSA) (00211*) | luxuriant | Oxacillin OX 1 mcg | Very Hazy to No Zone | 34-36°C 24 hours |
| Cefoxitin CX 30 mcg | <=21 mm | |||
| Pseudomonas aeruginosa ATCC 27853 (00025*) | luxuriant | Ceftazidime CAZ 30 mcg | 22-29 mm | 34-36°C 16-20 hours |
| Ciprofloxacin CIP 5mcg | 25-33 mm | |||
| Tobramycin TOB 10 mcg $ | 20-26 mm | |||
| Amikacin AK 30 mcg $ | 20-26 mm | |||
| Aztreonam AT 3mcg | 23-29 mm | |||
| Cephotaxime CTX 30 mcg | 18-22 mm | |||
| Gentamicin GEN 10 mcg $ | 17-23 mm | |||
| Imipenem IPM 10 mcg | 20-28 mm | |||
| Piperacillin PI 100 mcg | 25-33 mm | |||
| Piperacillin Tazobactum PIT 30/6 mcg | 23-29 mm | |||
| Enterococcus faecalis ATCC 29212 (00087*) | luxuriant | Trimethoprim TR 5 mcg # | 24-32 mm | 34-36°C 16-20 hours |
| Ampicillin AMP 2 mcg | 15-21 mm | |||
| Imipenem IPM 10 mcg | 24-30 mm | |||
| Linezolid LZ 10 mcg | 19-25 mm | |||
| Nitrofurantoin NIT 100 mcg | 18-24 mm | |||
| Co-Trimoxazole (COT) 25 mcg | 26-34 mm | |||
| Vancomycin VA 5 mcg | 10-16 mm | |||
| Enterococcus faecalis ATCC 33186 (00210*) | luxuriant | Co-Trimoxazole (COT) 25 mcg | <=20 mm | 34-36°C 16-20 hours |
| Streptococcus pneumoniae ATCC 49619 | luxuriant | Vancomycin VA 5 mcg | 17-23 mm | 34-36°C 18-20 hours |
| Haemophilus influenzae ATCC 49247 | luxuriant | Ampicillin AMP 2 mcg | 6-12 mm | 34-36°C 18-20 hours |
| Haemophilus influenzae ATCC 49766 | luxuriant | Cefixime CFM 5 mcg | 29-35 mm | 34-36°C 18-20 hours |
Key : *Corresponding WDCM numbers.
Storage and Shelf Life
Store between 10-30°C in a tightly closed container and the prepared medium at 20-30°C. Use before expiry date on the label. On opening, product should be properly stored dry, after tightly capping the bottle in order to prevent lump formation due to the hygroscopic nature of the product. Improper storage of the product may lead to lump formation. Store in dry ventilated area protected from extremes of temperature and sources of ignition Seal the container tightly after use. Product performance is best if used within stated expiry period.
Disposal
User must ensure safe disposal by autoclaving and/or incineration of used or unusable preparations of this product. Follow established laboratory procedures in disposing of infectious materials and material that comes into contact with clinical sample must be decontaminated and disposed of in accordance with current laboratory techniques (3,5).
References
- Murray P. R., Baron J. H., Pfaller M. A., Jorgensen J. H. and Yolken R. H., (Ed.), 2003, Manual of Clinical Microbiology, 8th Ed., American Society for Microbiology, Washington, D.C.
- National Committee for Clinical Laboratory Standards, 2000, Approved Standard: M7-A5. Methods for Dilution Antimicrobial Susceptibility Tests for Bacteria that grow aerobically, 5th Ed., NCCLS, Wayne, Pa.
- Isenberg, H.D. Clinical Microbiology Procedures Handbook. 2nd Edition.
- MacFaddin J. F., 1985, Media for Isolation-Cultivation-Identification-Maintenance of Medical Bacteria, Vol. 1, Williams and Wilkins, Baltimore
- Jorgensen, J.H., Pfaller, M.A., Carroll, K.C., Funke, G., Landry, M.L., Richter, S.S and Warnock., D.W. (2015) Manual of Clinical Microbiology, 11th Edition. Vol. 1.
- Present Status and Future Work, WHO Sponsored collaborative study, Chicago, Oct. 1967.
- Ericsson H. M. and Sherris J. L., 1971, Acta Pathol. Microbiol., Scand. Sect B Suppl., 217:1.
- NCCLS Approved Standard: ASM-2, 1979, Performance Standards for Antimicrobic disc Susceptibility Tests, 2nd Ed.,National Committee for Clin. Lab. Standards.
- Mueller J. H. and Hinton J., 1941, Proc. Soc. Exp. Biol. Med., 48:330.
- Performance Standards of Antimicrobial Susceptibility Testing; 34th Edition. M100-Ed34, Vol.44, No.5, Jan-2024.
- ISO/TS 16782:2016, Confirmed in 2021 Clinical laboratory testing - Criteria for acceptable lots of dehydrated Mueller-Hinton agar and broth for antimicrobial susceptibility testing
- European Committee on Antimicrobial Susceptibility Testing Breakpoint tables for interpretation of MICs and zone diameters Version 14.0, valid from 2024-01-01.
- European Committee on Antimicrobial Susceptibility Testing Routine and extended internal quality control as recommended by EUCAST Version 14.0, valid from 2024-01-01.
| Product Name | Mueller Hinton Agar |
|---|---|
| SKU | M173 |
| Product Type | Regular |
| Physical Form | Powder |
| Origin | Animal |
| Packaging type | HDPE |
| References | 1. Mueller J. H. and Hinton J., 1941, Proc. Soc. Exp. Biol. Med., 48:330. 2.National Committee for Clinical Laboratory Standards, 2000, Approved Standard: M7-A 5.Methods for DilutionAntimicrobial Susceptibility Tests for Bacteria that grow aerobically, 5th Ed., NCCLS, Wayne, Pa. 3.NCCLS Approved Standard: ASM-2, 1979, Performance Standards for Antimicrobic disc Susceptibility Tests, 2nd Ed.,National Committee for Clin. Lab. Standards. 4.Bauer A. W., Kirby W. M., Sherris J. L. and Turck M., 1966, Am. J. Clin. Pathol., 45:493. 5.Present Status and Future Work, WHO Sponsored collaborative study, Chicago, Oct. 1967. 6.Ericsson H. M. and Sherris J. L., 1971, Acta Pathol. Microbiol., Scand. Sect B Suppl., 217:1. 7.National Committee for Clinical Laboratory Standards, 1986, Proposed Standards, M6-P, NCCLS, Villanova, Pa. 8.MacFaddin J. F., 1985, Media for Isolation-Cultivation-Identification-Maintenance of Medical Bacteria, Vol. 1, Williamsand Wilkins, Baltimore 11.Jorgensen,J.H., Pfaller , M.A., Carroll, K.C., Funke, G., Landry, M.L., Richter, S.S and Warnock., D.W. (2015)Manual of Clinical Microbiology, 11th Edition. Vol. 1. |
| Customized Product Available | No |